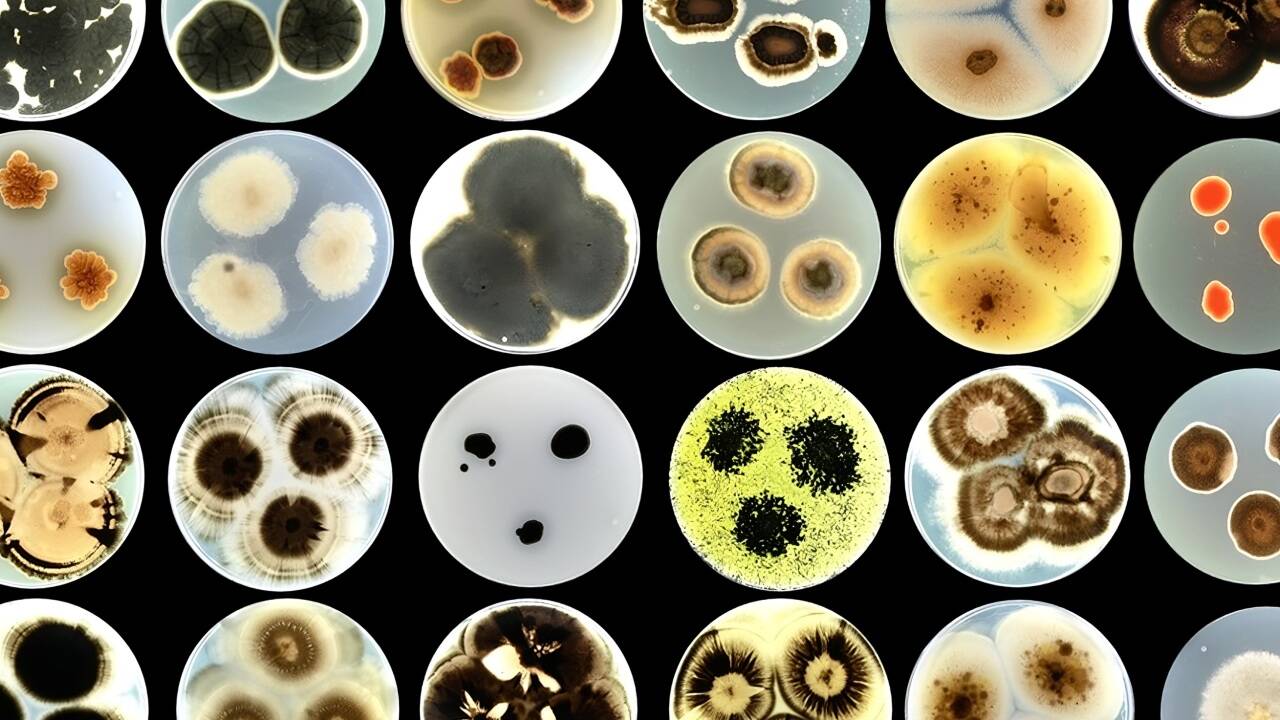

Außenwände bilden die tragenden und schützenden Hüllen eines Gebäudes. Über ihre klassischen Aufgaben hinaus übernehmen sie bisher noch keine zusätzlichen Funktionen. Ein internationales Team aus Forschenden und Unternehmen, an dem Carole Planchette vom Institut für Strömungslehre und Wärmeübertragung der TU Graz beteiligt ist, möchte das nun ändern. Sie will Gebäudefassaden mikrobielles Leben einhauchen. Im Projekt Remedy arbeitet ein Konsortium daran, gezielt zusammengestellte Lebensgemeinschaften aus nützlichen Mikroorganismen, wie Pilzen und Algen, in Spezialtinte zu integrieren, die auf Außenwänden aus Beton, Holz, Metall und anderen Materialien haftet. Diese lebenden Gebäude-Tattoos sollen die Fassaden vor Verwitterung schützen, Kohlendioxid speichern und Schadstoffe aus der Luft filtern. Der European Innovation Council finanziert das auf vier Jahre angelegte Projekt im Rahmen des Pathfinder-Förderprogramms mit insgesamt knapp drei Millionen Euro.
Milliarden Quadratmeter potenzielle Wandfläche
Gemäß den Angaben der Europäischen Umweltagentur werden in den kommenden 25 Jahren EU-weit Gebäudefassaden und Dächer mit einer Gesamtfläche von 9,4 Mrd. Quadratmetern renoviert oder neu gebaut. "Das ist ein sehr großes Potenzial, das wir nutzen sollten. Mikrobiologische Lebensgemeinschaften auf Dächern und Fassaden könnten zahlreiche Funktionen übernehmen, ohne dabei knappe, unbebaute Flächen zu beanspruchen", sagt Carole Planchette.
Nützliches Mikrobiom für Gebäude
An der Universität Laibach sucht ein Team um die Mikrobiologin Nina Gunde-Cimerman nach geeigneten Mikroorganismen. Die Forschenden wollen verschiedene Mikroben mit unterschiedlichen Eigenschaften kombinieren, die zusammen eine stabile Gemeinschaft bilden. "Das Ziel ist ein nützliches Mikrobiom für Gebäude, das widerstandsfähig gegen schädliche Mikroben ist und oberflächliche Risse selbstständig repariert", sagt Carole Planchette. Am Institut für Strömungslehre und Wärmeübertragung der TU Graz ist Carole Planchette dafür verantwortlich, eine geeignete, druckfähige Tinte zu entwickeln, in der die Mikroorganismen überleben. "Wir haben uns für den Inkjet-Druck entschieden, weil wir damit die lebende Tinte sehr präzise, kontrolliert und schnell zugleich auftragen können", erklärt Carole Planchette. Eine Herausforderung sind die Dimensionen der Mikroorganismen, die eine Größe von mehreren Mikrometern erreichen und unter Umständen größere Cluster bilden können. Damit sind sie zu groß für die klassische Inkjet-Technologie, bei der Partikel im Nanometerbereich versprüht werden. Gemeinsam mit dem slowakischen Inkjet-Hersteller Qres Technologies und dem österreichischen Beschichtungsspezialisten Tiger Coatings arbeitet Carole Planchette an den notwendigen technologischen Modifikationen.
Personalisiertes Architekturdesign
"Im Projekt Remedy wollen wir grundlegende Fortschritte im Bereich der Mikrobiologie und synthetischen Biologie erzielen und das Know-how in die Materialwissenschaft übertragen", sagt Projektkoordinatorin Anna Sandak vom Forschungsinstitut InnoRenew CoE in Izola, Slowenien.
"Mit geeigneten Biofabrikationsverfahren soll dann ein personalisiertes Design in der Architektur möglich werden. Ich bin zuversichtlich, dass wir innerhalb der Projektlaufzeit geeignete Tinten und die angepasste Inkjet-Technologie entwickeln", sagt Carole Planchette. "Ich rechne auch damit, dass wir passende Mikroorganismen finden, die in der Tinte und unter dem Stress des Druckvorgangs überleben." Die größte Herausforderung in den vier Jahren werde es sein, diesen Prozess vollständig reproduzierbar gestalten zu können. "Denn lebende - also sich wandelnde - Tinten für industrielle Prozesse wie den Tintenstrahldruck zu verwenden, die nur sehr geringe Parameterschwankungen tolerieren, ist absolutes Neuland."